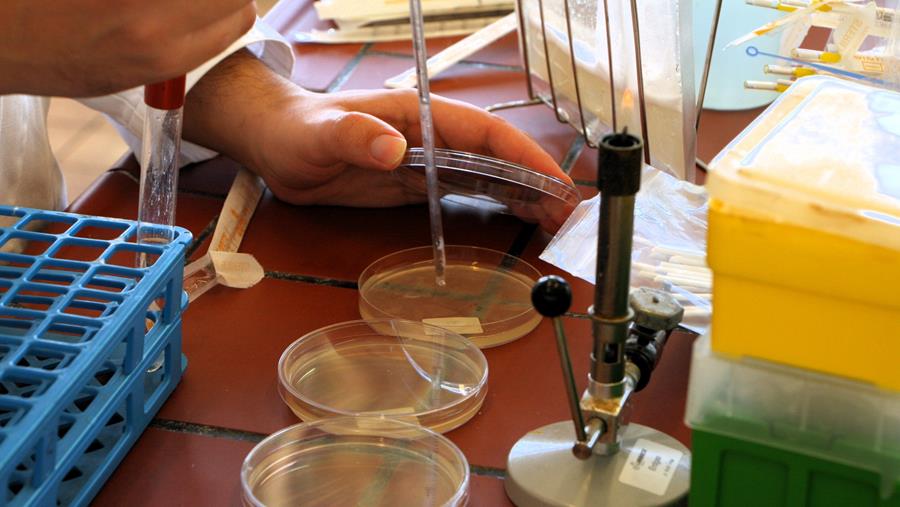
Hoe de houdbaarheid handhaven bij mono-, biodegradeerbare en dunnere verpakkingsmaterialen?

- 04 november 2024
- Door Erik Kruisselbrink
- | Bron: Verpakking & Label
Hoe de houdbaarheid handhaven bij mono-, biodegradeerbare en dunnere verpakkingsmaterialen?
Gedwongen door de trend naar milieuvriendelijkere verpakkingen zijn dunnere, biodegradeerbare en monomateriaal-verpakkingen in opkomst. Maar welke gevolgen heeft dat voor de microbiële houdbaarheid en veiligheid van het verpakte voedingsmiddel?
Sorry, dit is een premium artikel
Dit artikel is exclusief beschikbaar voor abonnees. Abonneer je nu en krijg toegang tot alle artikels.
Ontdek onze abonnementsformules